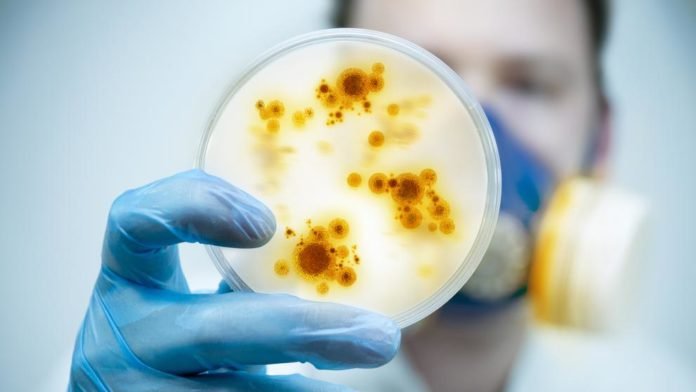

Las autoridades sanitarias de Perú han confirmado un nuevo brote del síndrome de Guillain-Barré (SGB), una enfermedad autoinmune rara que ya ha afectado a una cincuentena de personas en cuatro provincias del país. Puesto que no es contagioso, el riesgo para los viajeros no es elevado aunque conviene tomar ciertas precauciones básicas.
La alerta la ha lanzado el Gobierno peruano, que ha decretado una emergencia sanitaria, aunque todavía no ha sido difundida por la Organización Mundial de la Salud (OMS). La ministra de Salud, Zulema Tomás, ha informado a la agencia Efe de un aumento inusual de casos del SGB en Junin (en el interior de la zona central) y en Piura, Lambayeque y La Libertad, en el norte del país.
Aunque el SGB raramente es mortal y generalmente es reversible, puede dejar secuelas
Según las autoridades sanitarias de Perú, el brote de SGB se ha producido en las mismas fechas que el año pasado, facilitado por el cambio de estación. La incidencia regular del SGB es de entre 200 y 300 casos por año, cifra que se puede duplicar en el 2019.
De momento se han contabilizado 20 casos en Piura, región fronteriza con Ecuador, 25 en La Libertad, también en el norte de Perú, y otros tres en Junin, pero se desconoce el origen del brote.
En opinión de Antoni Trilla, jefe del servicio de medicina preventiva y epidemiología del hospital Clínic de Barcelona, el síndrome de Guillain-Barré puede producirse por una bacteria como la Campylobacter, asociada a la ingestión de alimentos, o por un virus como enterovirus, Zika o la gripe.
El SGB es una enfermedad autoinmune poco habitual en la que el paciente presenta una infección por bacterias o virus, contra la cual el cuerpo genera anticuerpos y estos acaban atacando las células nerviosas y van destruyendo la melina, la funda protectora de los nervios.
Aunque el SGB raramente es mortal y generalmente es reversible, puede dejar secuelas. El tratamiento será más efectivo cuanto más accesible sea una UCI, para dar soporte vital mientras remite la dolencia, expone Antoni Trilla.
Las consecuencias en forma de problemas neurológicos pueden ser múltiples, desde la parálisis de una extremidad a la afectación del sistema nervioso central con capacidad de bloquear la musculatura respiratoria, lo que convierte en imprescindible la conexión a un respirador artificial.